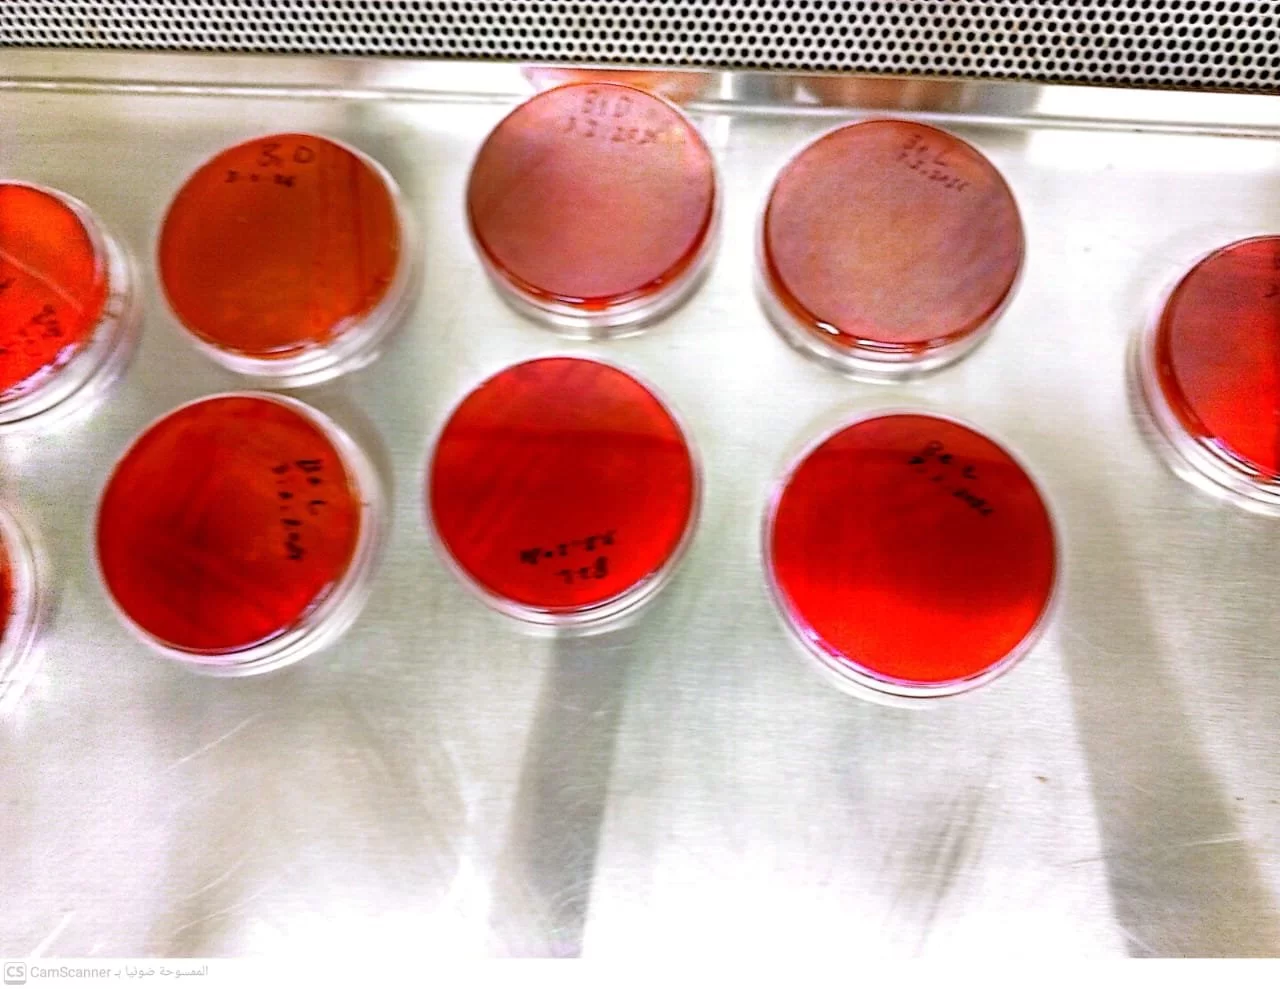

جامعة طرابلس
المزيد ...حول جامعة طرابلس
أنشئت الجامعة الليبية بموجب مرسوم ملكي بتاريخ 15 ديسمبر سنة 1955م، وكانت النواة الأولى لها كلية الآداب والتربية ببنغازي. في سنة 1957م تم إنشاء كلية العلوم، النواة الأولى لجامعة طرابلس. وفي سنة 1966م أنشأت كلية الزراعة، وفي عام 1961م قامت منظمة الأمم المتحدة للتربية والعلوم والثقافة (اليونيسكو) باستحداث كلية الدراسات الفنية العليا التي ضمت إلى الجامعة الليبية عام 1967م باسم كلية الهندسة. في سنة 1973م، فٌصلت الجامعة الليبية إلى جامعتين بنغازي وطرابلس. وفي عام 1976م تغيــّر اسمها إلى جامعة الفاتح. انفصلت الكليات الطبية سنة 2009م تحت مسمى جامعة الفاتح للعلوم الطبية، وأعيد ضمها من جديد سنة 2010م. سنة 2012 استعادت الجامعة تسميتها الأصلية. وتوالى إنشاء الكليات بجامعة طرابلس؛ ليصل في الوقت الحالي إلى 20 كلية.
حقائق حول جامعة طرابلس
أحصائيات من واقع قاعدة بيانات جامعة طرابلس
11804
المنشورات العلمية
3904
هيئة التدريس
67824
الطلبة
255
البرامج الدراسية
166679
الخريجون
1353
الطلبة الاجانب
12
الأساتذة الأجانب
أخبار جامعة طرابلس
2026-02-05
602
0
2026-01-04
755
0
2026-04-21
177
0
2026-04-21
14
0
2026-04-21
206
0
2026-04-21
45
0
2026-04-20
35
0
2026-04-20
30
0
2026-04-20
25
0
2026-04-20
24
0